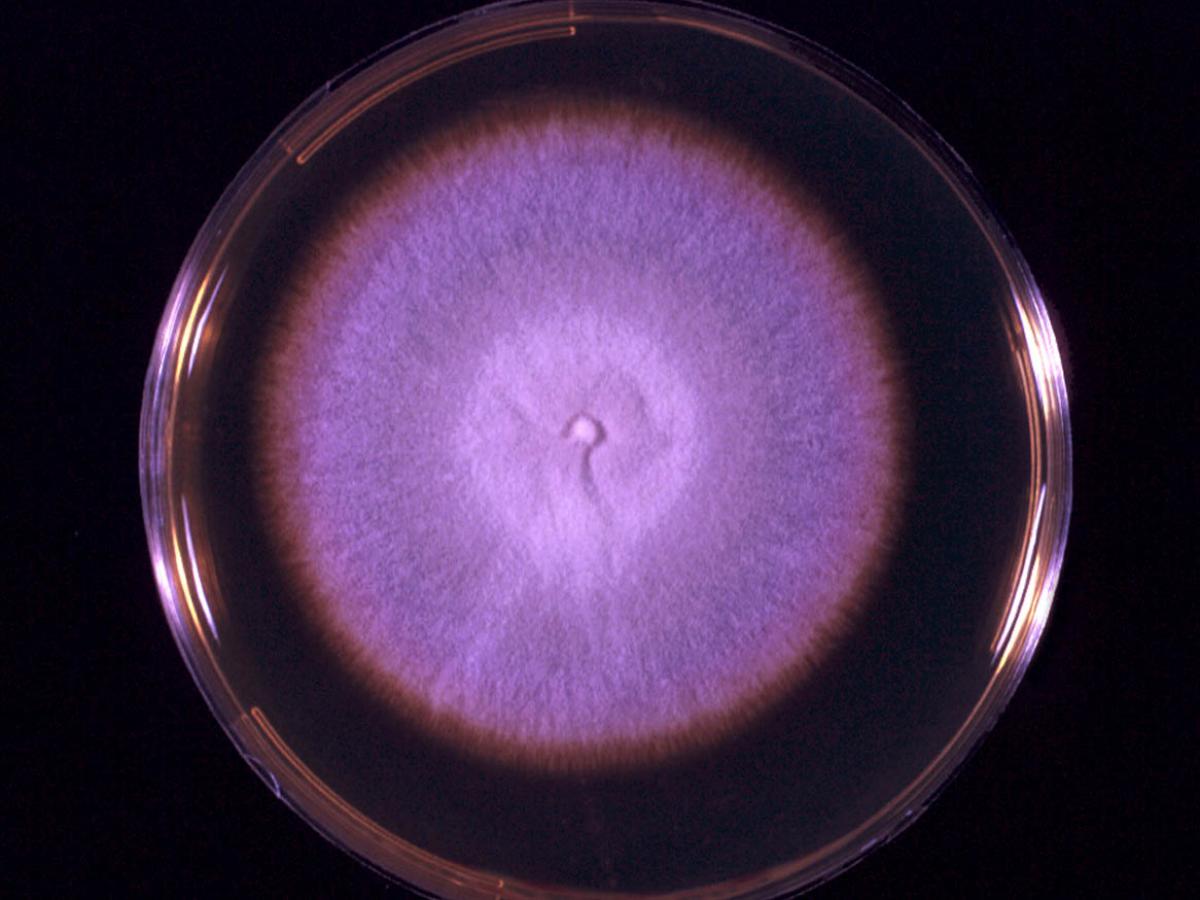
Culture
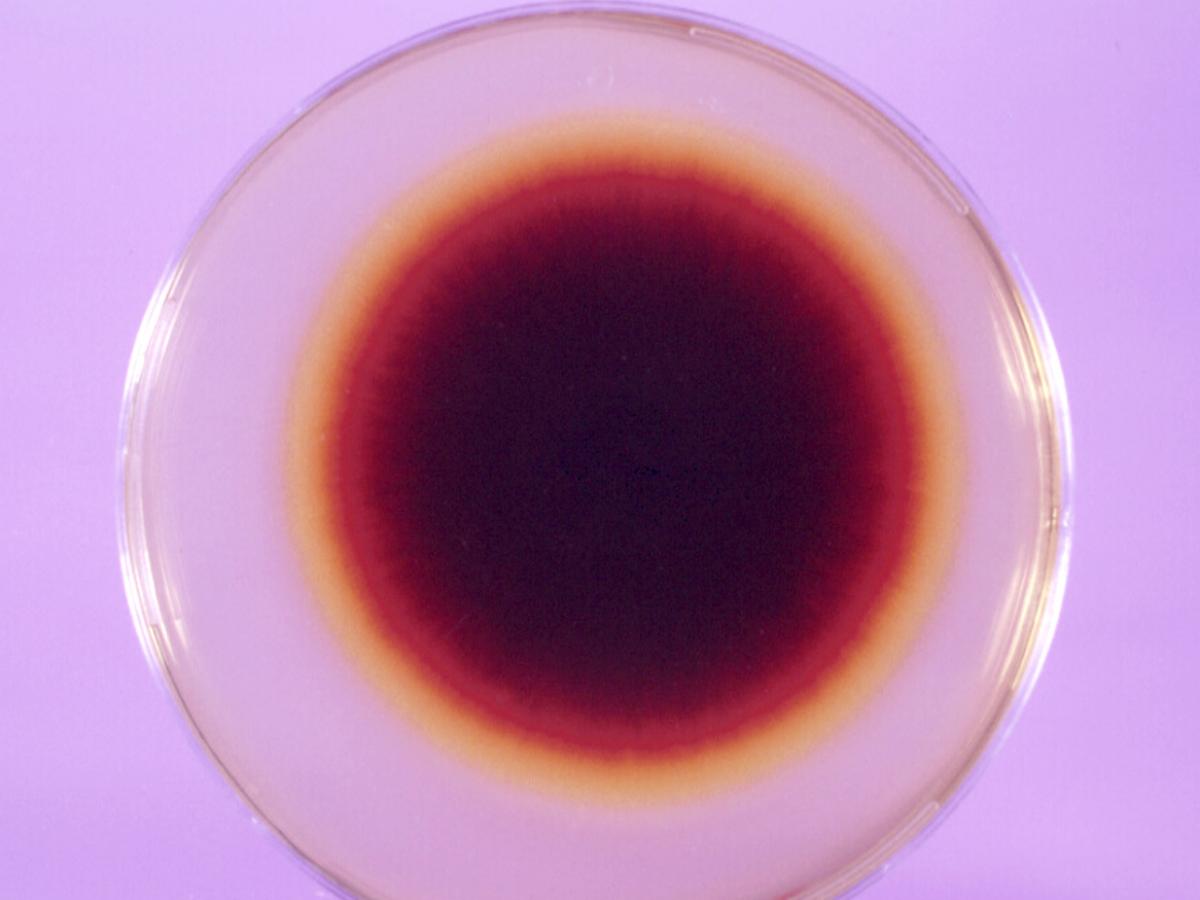
Unknown 79 culture - 2

Status message
Correct! Excellent, you have really done well. Please find additional information below.
Unknown 79 = Trichophyton equinum
Clinical presentation: Granulomatous lesion with a crusting border of two years duration on the wrist of a male stable hand caused by T. equinum.

Culture: Colonies are usually flat, but some may develop gentle folds or radial grooves, white to buff in colour, suede-like to downy in texture, and are similar to T. mentagrophytes. Cultures usually have a deep-yellow submerged fringe and reverse which later becomes dark red in the centre.

Microscopy: Microscopically, abundant microconidia which may be clavate to pyriform and sessile or spherical and stalked are formed laterally along the hyphae. Macroconidia are only rarely produced, but when present are clavate, smooth, thin-walled and of variable size. Occasional nodular organs may be present and the microconidia often undergo a transformation to produce abundant chlamydoconidia in old cultures. RG-2 organism.

Comment: Trichophyton equinum is a zoophilic fungus causing ringworm in horses and rare infections in humans. It is of world-wide distribution except for. var. autotrophicum which is restricted to Australia and New Zealand. Most strains require nicotinic acid for growth except those from Australia and New Zealand, which are autotrophic (var. autotrophicum). Invaded hairs show an ectothrix infection but do not fluoresce under Wood's ultra-violet light.
Key features: Culture characteristics, microscopic morphology and contact with horses.
About Trichophyton equinum Back to virtual assessment